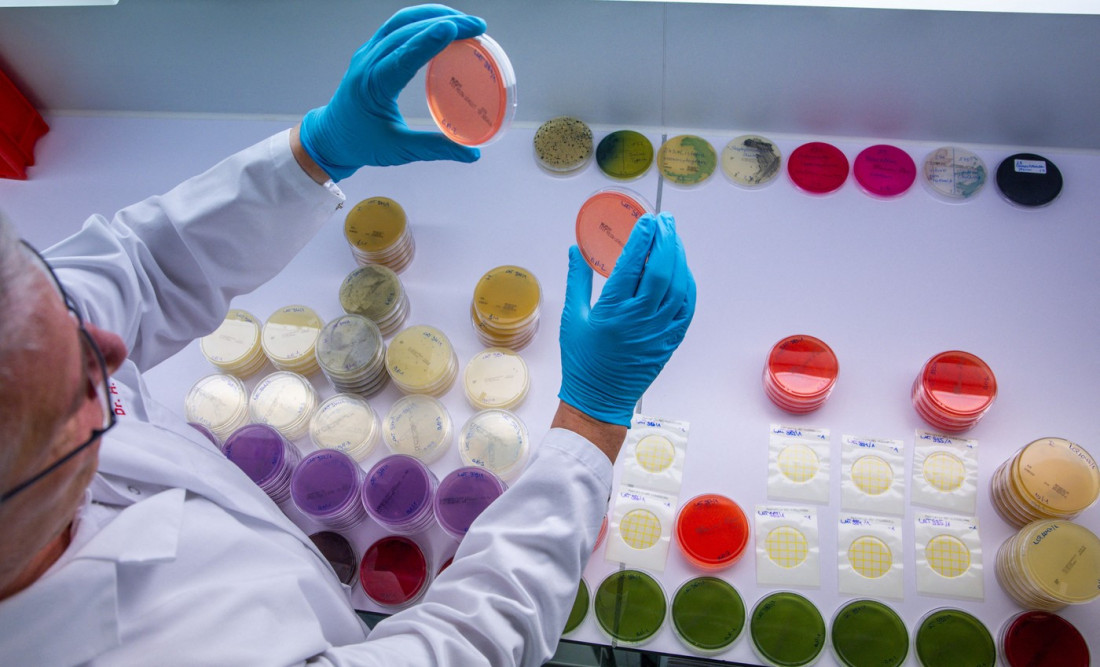

Aptamil AR1 povučen u Hrvatskoj: Tehnolog Srđan Đuričić objašnjava koliko je Bacillus cereus opasan za bebe
KomentariNakon što je Hrvatska agencija za poljoprivredu i hranu saopštila da je sa tržišta povukla hranu za bebe Aptamil AR1 zbog povećanog prisustva bakterije Bacillus cereus, Ministarstvo zdravlja Republike Srbije sprovelo je hitnu proveru da li je ovaj proizvod bio prisutan i na domaćem tržištu. Kako je potvrđeno iz Odeljenja granične sanitarne inspekcije Sektora za inspekcijske poslove, utvrđeno je da je navedeni proizvod uvezen na tržište Srbije početkom ove godine.
Povodom ove teme, za Euronews Srbija govorio je tehnolog Srđan Đuričić, koji je detaljno objasnio o kakvoj je bakteriji reč, koliko ona može biti opasna, naročito za najmlađu populaciju, kao i kako dolazi do ovakvih situacija u praksi.
Govoreći o samoj bakteriji, Đuričić je pojasnio da je Bacillus cereus poznata bakterija u prehrambenoj industriji.
"U pitanju je bakterija Bacillus cereus. To je, pre svega, bakterija koja je svima nama u svetu prehrambene industrije poznata. Ona se uglavnom nalazi u prirodi, u vodi, prašini, na biljkama. Ono što moramo da kažemo jeste da Bacillus cereus ima određene sojeve i nisu svi sojevi opasni. Opasni su oni sojevi koji stvaraju toksine", objasnio je Đuričić.
Kako je naveo, upravo ti toksini mogu izazvati ozbiljne zdravstvene reakcije kod osetljivih grupa.
"Toksini mogu izazvati akutne reakcije, mučninu i povraćanje, naročito kod beba. Kod starijih ljudi uglavnom nema problema, jer su oni imuni na ovakve vrste bakterija", rekao je on.
Đuričić je naglasio da se u proizvodnji hrane za bebe primenjuju najstroži mogući standardi.
"Ono što je bitno jeste da se u proizvodnji hrane za bebe koristi takozvana nulta tolerancija na rizik. Hrana se apsolutno i potpuno kontroliše kako ne bi došlo do bilo kakve pojave bakterija. Zbog toga je logično da se sprovode rigorozne kontrole, jer niko ne očekuje da do ovakve situacije može da dođe", rekao je sagovornik Euronews Srbija.
RUSLANAS BARANAUSKAS / Sciencephoto / Profimedia

Jedno od ključnih pitanja koje se nameće jeste kako je moguće da je proizvod nekoliko meseci bio na tržištu, a da se tek sada utvrdi prisustvo bakterije. Đuričić je pojasnio da dužina boravka proizvoda na tržištu ne znači da je on sve vreme bio nebezbedan.
"To što je proizvod dugo na tržištu ne znači da je on sve vreme bio nebezbedan. Proizvod se proizvodi u velikim količinama, u određenim šaržama. Svaka šarža se uzorkuje i prolazi određene provere. U ovom slučaju je mogla da postoji kontaminacija na jednoj ili na većem broju šarži", objasnio je on.
"Može doći i do pojave bakterije koja stvara spore u samom proizvodu, pa se nakon nekog vremena te spore aktiviraju i tada se bakterija otkriva. Svaka zemlja ima dodatne kontrole na svaki proizvod koji ulazi na njeno tržište i upravo na taj način je i došlo do otkrivanja kontaminacije", naveo je Đuričić.
On je istakao da u ovakvim situacijama, pored redovnih, odmah stupaju na snagu i vanredne kontrole.
"Pored redovnih kontrola, postoje i vanredne kontrole proizvoda. One se sprovode upravo kada dođe do prijave u nekoj drugoj zemlji da je otkriven proizvod sa kontaminacijom. Tada dolazi do vanrednih kontrola i u našoj zemlji, ali i u svim ostalim zemljama", rekao je Đuričić.
Ministarstvo zdravlja prati situaciju
Kako je objasnio, u takvim slučajevima primenjuje se takozvani princip predostrožnosti.
"Uveden je princip predostrožnosti koji ima za cilj da se, ukoliko se otkrije kontaminiran proizvod, taj proizvod odmah povuče sa tržišta kako ne bi došlo do kontakta sa potrošačem i eventualnih zdravstvenih problema. Ukoliko se isti ili sličan proizvod nađe u našoj zemlji, on se apsolutno povlači sa tržišta", naglasio je on.
Na pitanje da li je moguće da je bakterija nastala usled neadekvatnog skladištenja ili je proizvod već bio kontaminiran prilikom uvoza, Đuričić je istakao da bez detaljne istrage nije moguće dati konačan odgovor.
"Da bi proizvod bio uvezen u neku zemlju, on mora da prođe određene procese i procedure. Mora da ima ispravnu zdravstvenu dokumentaciju, da bude u skladu sa međunarodnim propisima, da prođe graničnu sanitarnu kontrolu i da bude mikrobiološki ispitan“, rekao je on.
Ipak, kako je dodao, uzrok kontaminacije može nastati u različitim fazama.
"U ovom trenutku, bez dodatne specijalne istrage i analiza, ne možemo sa sigurnošću reći gde je došlo do kontaminacije. Možemo samo da pretpostavimo da je možda došlo do lošeg skladištenja, oscilacija temperature ili lošeg transporta, gde je prekinut hladni lanac proizvoda. Sve to mora da ispita nadležna inspekcija kako bi se utvrdilo u kom delu je došlo do same kontaminacije", zaključio je Đuričić.
Ministarstvo zdravlja je saopštilo da se situacija prati i da će javnost biti blagovremeno obaveštena o svim daljim koracima i rezultatima kontrola

Komentari (0)